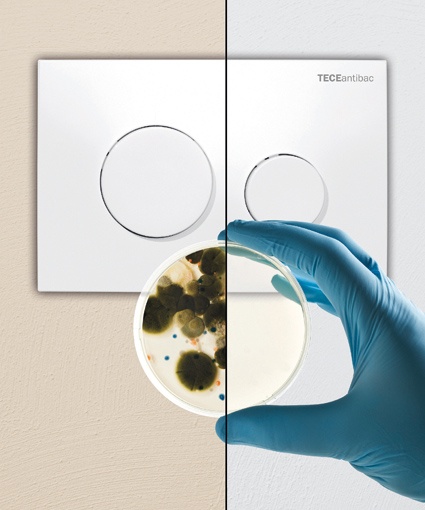
Photo

Antibakterielle Spülauslösung für mehr Hygiene am WC
Nach der Toilettenbenutzung geht der erste Griff bekanntlich zur Spülauslösung. So können beispielsweise Coli-Bakterien auf die WC-Betätigung gelangen und auf den nächsten Nutzer übertragen werden.
Der Emsdettener Haustechnikanbieter Tece hat spezielle WC-Betätigungen mit antibakterieller Wirkung entwickelt, die das Risiko des Keimwachstums auf der Spülauslösung minimieren.
Anwendungsbereiche sieht der Hersteller in allen hygienisch anspruchsvollen Umgebungen, beispielsweise in Krankenhäusern, Pflegeheimen und anderen öffentlichen und halböffentlichen Bereichen. Die Spülauslöser eignen sich jedoch auch für private Bäder, die hohe Anforderungen an die Hygiene erfüllen sollen. Mit ambia und loop von Tece stehen hierfür zwei ästhetisch ansprechende Platten-Designs zur Verfügung.
Die WC-Betätigungen bestehen aus einem speziellen Kunststoff, der mit Silberionen durchsetzt ist. Die Silberionen entziehen den Keimen die Lebensgrundlage und hemmen damit das Wachstum der Krankheitserreger. Die Wirksamkeit der Platte bleibt über die gesamte Lebensdauer erhalten, denn die Silberionen sind im Kunststoff gebunden. Der Silberwirkstoff hemmt das Bakterienwachstum von Anfang an, sodass sich große Keimmengen gar nichterst entwickeln können.
Der spezielle Kunststoff ist gesundheitlich absolut unbedenklich. Der Werkstoff entspricht der europäischen Richtlinie 2002/72/EC und erfüllt damit die hohen Anforderungen an Kunststoffe, die mit Lebensmitteln in Kontakt kommen.
Zwei Prüfinstitute bestätigen dessen antibakterielle Wirkung: das deutsche Forschungsinstitut Hohenstein, Bönnigheim, und die Schweizer Sanitized, Burgdorf. Die Institute bestätigen dem Kunststoff eine Keimreduktion von durchschnittlich über 99,7% (Hohenstein) bzw. 99,9% (Sanitized).
Die WC-Betätigungen aus antibakteriellem Kunststoff sind durchaus erschwinglich: Sie kosten nur wenig mehr als normale Betätigungen. Der Anbieter bietet die Spülauslösungen passend zum eigenen Spülkasten für die wassersparende Zweimengenspültechnik, aber auch für die Einmengentechnik. Mit ambia und loop stehen zudem zwei ästhetisch ansprechende Platten-Designs zur Verfügung.










